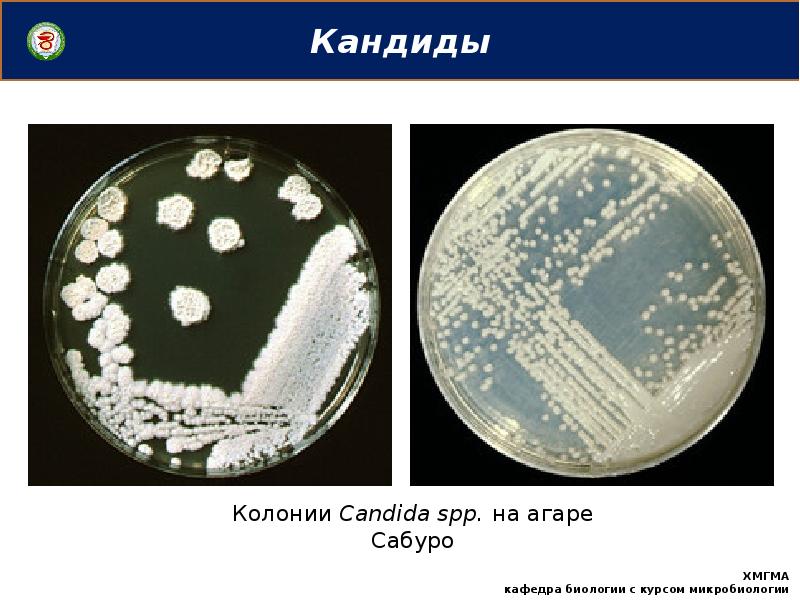

Описание кандиды
Что такое этика 4 класс кратко
Спа комплекс алтай
Превенар 13 побочные эффекты
Звонки старых мобильных
Жаль подмога не пришла подкрепление текст
Предоставить копии учредительных документов
Акела из маугли
Rufua
Банк втб уставной капитал
23 маната
Lga1366 кулер
Снять квартиру метро измайловская москва
Товары для сноуборда
Описание кандиды 114 фотографий